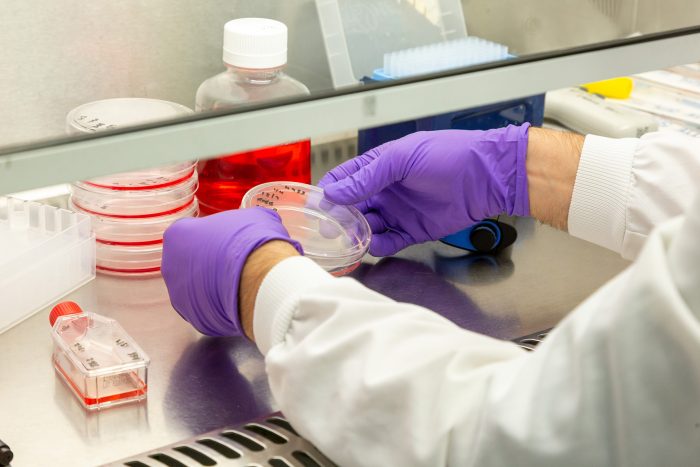

Below, you can explore some of our recent still photography projects. These examples showcase the variety of work we’ve done across different industries, highlighting our ability to capture the essence of each subject with precision and creativity.
Professional Still Photography
We provide high-quality still photography for housing developers, hotels, product manufacturers, commercial property firms, public sector organisations, and charities. Our industry experience ensures tailored, professional imagery that meets each client’s needs.
Our still photography services cover a wide range of styles, including still life, action shots, and property photography. With years of experience working in various environments, whether it’s a bustling city, serene countryside, or in a controlled studio setting, we bring a professional approach to every project.
Our team has honed the skills necessary to capture both intricate details and dynamic moments, tailoring each shot to your specific needs. From showcasing the unique features of a property to creating visually striking still life compositions, we ensure that every image is carefully composed and expertly lit. No matter the environment or subject, we deliver high-quality, compelling visuals that tell your story with precision and creativity.
We also offer a worldwide travel option for those special projects. No matter the location, we are ready to travel and capture your imagery with the same high-quality standards, ensuring your vision comes to life wherever you need us.
Our property and show home photography options are a popular choice for many clients. You can read more about these services and explore the packages we offer on our dedicated property photography page.
Professional Photography
Shoots from £250
- We provide high-resolution imagery, perfect for both online and offline use. Whether you need sharp, detailed visuals for websites, brochures, banners, or other marketing materials, our images are designed to maintain clarity and impact across all platforms.
- Shot by award-winning photographers with global experience, our images are crafted with expertise and creativity. Having travelled the world capturing stunning visuals, our team brings a unique perspective to every project, ensuring exceptional results every time.
- We specialise in a wide range of photography styles, including architectural, lifestyle, portrait, action, and property photography. Whether you’re showcasing a stunning building, capturing dynamic moments, or presenting a personal portrait, our team ensures each shot is perfectly composed and expertly lit to tell your story.
- We also offer drone photography, providing stunning aerial shots to showcase properties, landscapes, and developments from a unique perspective. We are CAA licensed for UK drone flights and fully insured, ensuring safe and professional aerial imagery for your projects.